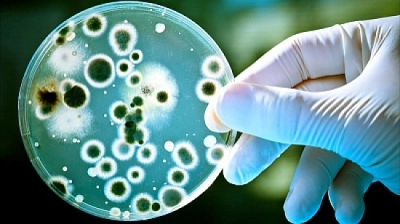

|
||||||||
|
|
||||||||
|
Tu tiempo 00:00
|
||||||||
|
Tiempo promedio
00:00
|
||||||||
|
Mejor tiempo
--:--
|
||||||||
 |
||||||||
|
|
||||||||
|
|||||||||||||||||||||||||||||
virus y bacteriasEste rompecabezas pertenece al propietario del álbum My Album Propietario del álbum: FELIPE CASTRO
Campeón actual: Not set yet Credenciales y derechos de autor: Armar rompecabezas |
||||||
| virus y bacterias - 25 piezas | |||||
| Tu tiempo: |
|
||||
| ¿Mostrar piezas del rompecabezas de mayor tamaño detrás de las piezas más pequeñas? Sí No | |
| Compartir este rompecabezas |
|
| |